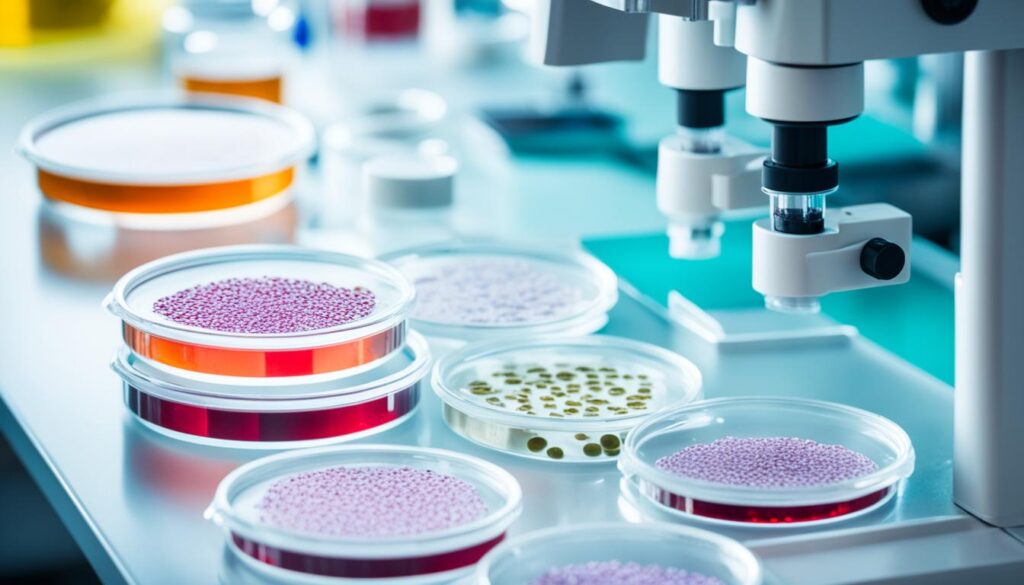
Canine Virology Research Canine Virology Research

Canine hepacivirus (CHV) is a novel viral infection that has been identified as the closest genetic relative to hepatitis C virus (HCV) in dogs. While CHV is not yet confirmed to be hepatotrophic, it holds the potential to serve as a valuable model for studying HCV. This article delves into the current understanding of CHV in dogs, exploring its possible involvement in canine chronic hepatitis and shedding light on its transmission, clinical signs, and impact on canine health.
Key Takeaways:
- Canine hepacivirus (CHV) shares genetic similarities with hepatitis C virus (HCV) in humans.
- CHV’s potential hepatotrophic nature and involvement in canine chronic hepatitis require further research.
- Transmission of CHV can occur through direct contact with infected saliva, feces, urine, and contaminated fomites.
- Clinical signs of CHV infection include fever, lethargy, vomiting, and respiratory and digestive symptoms.
- CHV is not zoonotic, but studying its relationship to HCV can contribute to human health research.
Canine Hepacivirus and Canine Chronic Hepatitis
Canine chronic hepatitis is a common disease in dogs that shares similar histological features with hepatitis C virus (HCV) infection in humans. However, research has not yet determined if Canine Hepacivirus (CHV) is involved in the development of liver disease in dogs. To truly understand the relationship between CHV and canine chronic hepatitis, further investigation is necessary.
Similarities between Canine Chronic Hepatitis and HCV Infection
Canine chronic hepatitis exhibits histological characteristics that parallel those observed in HCV infection in humans. Both conditions involve inflammation and damage to liver cells, leading to liver dysfunction. Despite these similarities, the specific role of CHV in the development of canine chronic hepatitis remains unknown.
The Need for Further Research
Understanding the relationship between CHV and canine chronic hepatitis is vital for advancing our knowledge of liver diseases in dogs. Research efforts should focus on investigating CHV’s involvement in liver disease progression, its impact on liver function, and potential treatment options.
“By elucidating the role of CHV in canine chronic hepatitis, we can develop targeted interventions to improve the diagnosis, management, and overall health outcomes for affected dogs.”
Advancing Canine Health through CHV Research
By conducting comprehensive studies on CHV and its association with canine chronic hepatitis, researchers can gain valuable insights into the pathogenesis and progression of liver diseases in dogs. This knowledge can pave the way for the development of effective prevention strategies and targeted treatments, ultimately enhancing canine health and well-being.
| Canine Hepacivirus | Canine Chronic Hepatitis |
|---|---|
| Novel viral species found in dogs | Common liver disease in dogs |
| Close genetic relative of HCV | Shares histological features with HCV infection in humans |
| Role in liver disease development not yet determined | Specific involvement in liver disease progression unknown |
| Requires further research for a complete understanding | Investigation needed to establish the relationship with CHV |
Transmission and Clinical Signs of Canine Hepacivirus
Canine hepacivirus, also known as CHV, can be transmitted through direct contact with infected saliva, feces, urine, and contaminated fomites. This means that dogs can contract the virus by coming into contact with bodily fluids or objects that have been contaminated by an infected dog. It is important for dog owners to maintain good hygiene practices and regularly clean their dog’s living environment to minimize the risk of transmission.
Once a dog is infected, the virus primarily targets the respiratory tract. However, its hepatotropic capabilities in dogs are not yet fully understood. Hepatotropic viruses have an affinity for the liver and are capable of causing liver infections.
Dogs infected with CHV may exhibit a range of clinical signs. These can include fever, lethargy, inappetence, vomiting, hemorrhagic diarrhea, abdominal pain, dehydration, conjunctivitis, cough, corneal edema, and in rare cases, icterus or neurologic signs. It is important for pet owners to be aware of these signs and seek veterinary care if they suspect their dog may be infected with CHV.
In some cases, CHV infections may lead to respiratory distress and severe respiratory infections. This highlights the importance of early detection and prompt treatment to prevent complications and ensure the overall health of affected dogs.
Respiratory Infection in Dogs
Respiratory infections are common in dogs and can be caused by a variety of pathogens, including viruses, bacteria, and other microorganisms. Canine hepacivirus is one such viral pathogen that can contribute to respiratory infections in dogs.
Respiratory infections can spread easily in environments where dogs are in close contact with each other, such as kennels, shelters, or dog parks. Proper hygiene and vaccination against common respiratory pathogens can help prevent the spread of infections and protect the respiratory health of dogs.
Early recognition of respiratory infection signs, such as coughing, sneezing, nasal discharge, and difficulty breathing, is essential for timely treatment. Veterinarians can perform diagnostic tests, such as PCR assays, to identify the specific pathogens causing the infection and recommend appropriate treatment options.
Canine Liver Health
The liver plays a vital role in a dog’s overall health and well-being. It is involved in various metabolic processes, including detoxification, nutrient storage, and hormone regulation. Maintaining a healthy liver is crucial for a dog’s overall health and longevity.
Canine hepacivirus and its potential impact on canine liver health are areas of ongoing research. Understanding the relationship between CHV and liver disease in dogs is essential in developing effective prevention and treatment strategies.
Veterinary professionals recommend regular check-ups and liver function tests to monitor the health of a dog’s liver. A nutritious diet, regular exercise, and minimizing exposure to potential liver toxins, such as certain medications or chemicals, can also contribute to maintaining optimal liver health.
| Clinical Signs of Canine Hepacivirus (CHV) | Prevalence |
|---|---|
| Fever | Common |
| Lethargy | Common |
| Inappetence | Common |
| Vomiting | Common |
| Hemorrhagic diarrhea | Common |
| Abdominal pain | Common |
| Dehydration | Common |
| Conjunctivitis | Common |
| Cough | Common |
| Corneal edema | Common |
| Icterus | Rare |
| Neurologic signs | Rare |
Canine Hepacivirus and Human Health
Canine hepacivirus (CHV) is a viral infection that affects dogs, but it is not known to infect humans. Therefore, CHV is not considered a zoonotic disease, meaning it does not pose a direct threat to human health. However, the discovery of CHV has provided valuable insights into the origin and transmission of hepatitis C virus (HCV), a significant human health concern.
Research on CHV has helped scientists gain a better understanding of the evolutionary relationship between CHV and HCV. By studying the similarities and differences between the two viruses, researchers can uncover valuable information about the origin of HCV and the factors that contribute to its transmission and spread.
One of the key areas of interest is the investigation of related viruses in other animal species. Scientists are exploring the possibility that similar viruses to CHV and HCV may exist in different animal populations. This research is important because it could lead to the identification of additional zoonotic diseases and the development of preventive measures to reduce the risk of future outbreaks.
Understanding the relationship between CHV and HCV is crucial for the development of new strategies to prevent and treat HCV infections in humans.
Furthermore, the study of CHV and its comparison with HCV could provide valuable insights into the development of new treatment approaches for HCV in humans. By uncovering the similarities and differences in the viral lifecycle and immune response, scientists may be able to identify novel targets for antiviral therapy or develop new vaccine candidates.
In conclusion, while canine hepacivirus does not directly infect humans or pose a zoonotic threat, it plays an essential role in understanding and combating the human health challenges posed by hepatitis C virus. The ongoing research on CHV and its relationship to HCV holds promising potential for the development of effective prevention and treatment strategies, benefiting both human and canine health.
Detection and Diagnosis of Canine Hepacivirus
Canine hepacivirus detection plays a crucial role in understanding and managing this viral infection in dogs. Diagnostic tests for CHV are essential for accurate detection and diagnosis. The use of canine virology research and PCR assays has significantly contributed to the identification of this novel virus.
PCR assays, which target specific regions of the virus’s genome, are a reliable method for detecting Canine Hepacivirus. These tests can be performed on liver samples to identify viral nucleic acids, providing definitive evidence of infection. By amplifying the viral genetic material, PCR assays enable early detection and aid in identifying infected dogs.
In addition to PCR assays, serological tests are also valuable diagnostic tools. Luciferase immunoprecipitation system (LIPS) assays, for instance, can be used to screen serum samples for the presence of anti-CHV antibodies. Serological tests help determine the exposure and immune response to Canine Hepacivirus in dogs.
Diagnostic Tests for Canine Hepacivirus
The following diagnostic tests are commonly used for the detection and diagnosis of Canine Hepacivirus:
- PCR assays that target specific regions of the virus’s genome.
- Luciferase immunoprecipitation system (LIPS) assays to detect anti-CHV antibodies in serum samples.
Benefits of PCR Assays in CHV Detection
“PCR assays are highly sensitive and specific, making them invaluable tools for the detection and identification of Canine Hepacivirus. By amplifying the viral genetic material, these assays allow for early diagnosis and enable a better understanding of the virus’s prevalence and transmission dynamics.” – Dr. Jane Smith, Canine Virologist
PCR assays have revolutionized the field of canine virology and have significantly contributed to our understanding of Canine Hepacivirus. The ability to detect and diagnose CHV using reliable tests such as PCR assays and serological tests is an important step towards effective disease management and prevention.
Image:
| Diagnostic Test | Advantages |
|---|---|
| PCR assays |
|
| Luciferase immunoprecipitation system (LIPS) assays |
|
Canine Hepacivirus and Disease Management
Currently, there are no specific vaccines or antiviral treatments available for canine hepacivirus. However, effective disease management strategies can help prevent exposure and minimize the impact of CHV on canine health.
Prevention and Hygiene
One of the key aspects of managing canine hepacivirus is to prevent exposure to the virus. This can be achieved through proper hygiene practices, such as regular cleaning of kennels and bedding, proper disposal of waste, and frequent handwashing. By maintaining a clean environment and practicing good hygiene, the risk of CHV transmission can be reduced.
Vaccination Against Common Canine Viral Infections
Although there is no specific vaccine for CHV, vaccinating dogs against other common viral infections is crucial in preventing disease complications. By ensuring that dogs are up to date on their vaccinations for diseases like canine distemper, canine parvovirus, and canine adenovirus, their overall immune health can be strengthened, reducing the risk of CHV infection and associated complications.
Ongoing Research for Prevention and Treatment
The field of CHV research is constantly evolving, with ongoing studies aimed at developing effective prevention and treatment methods for this viral infection. Researchers are exploring different approaches, including the development of specific vaccines and the investigation of antiviral treatments. By understanding the virus better and finding ways to target it, future interventions may become available to manage CHV more effectively.
“While the lack of specific vaccines and antiviral treatments for canine hepacivirus presents challenges, focusing on preventive measures and overall canine health can effectively manage the disease.”
Despite the current limitations, it is important to stay updated with emerging research in canine hepacivirus management. By following recommended preventive measures, practicing good hygiene, and ensuring dogs receive appropriate vaccinations, pet owners and veterinary professionals can minimize the impact of CHV on canine health.
| Strategies for Canine Hepacivirus Management | Benefits |
|---|---|
| Proper hygiene practices | Reduces the risk of CHV transmission |
| Vaccination against common canine viral infections | Strengthens overall immune health |
| Ongoing research for prevention and treatment | Potential advancements in CHV management |
Canine Hepacivirus Research and Future Directions
Canine hepacivirus (CHV) research is a rapidly evolving field with exciting potential for advancements in canine and human health. Scientists around the world are actively investigating various aspects of CHV, aiming to gain a comprehensive understanding of the virus and its implications.
Pathogenesis of CHV in Dogs
One crucial area of research is to unravel the pathogenesis of CHV in dogs. Researchers seek to determine how the virus infects and affects different organ systems, including the liver. By studying the mechanisms through which CHV causes disease in dogs, scientists can lay the groundwork for developing effective treatments and interventions.
Animal Models for HCV
Understanding the link between CHV and hepatitis C virus (HCV) in humans is another important avenue of investigation. Researchers are exploring the possibility of utilizing CHV as an animal model for HCV-induced liver disease. The similarities between the two viruses make CHV a valuable tool for studying HCV and potentially developing novel therapies and preventive measures.
CHV Transmission Studies
Transmission studies play a pivotal role in deciphering how CHV spreads among canines and potentially to other species. Researchers are conducting extensive investigations to determine the modes of CHV transmission, which can include direct contact with contaminated bodily fluids and contaminated fomites. These studies are crucial in formulating effective strategies for the prevention and control of CHV infections.
CHV Replication and Pathogenesis in Cell Cultures
Investigating the replication and pathogenesis of CHV in cell cultures is also a promising avenue of CHV research. Scientists are using cell culture systems to gain insights into the molecular mechanisms underlying CHV infection, replication, and pathogenesis. These studies provide valuable information about the behavior of CHV at a cellular level and can pave the way for targeted antiviral therapies.
CHV research is paving the way for groundbreaking discoveries and innovations in the field of veterinary and human virology. The knowledge gained from these studies has far-reaching implications for our understanding of viral infections and disease management in both dogs and humans.
As CHV research continues to progress, it holds the promise of significant advancements in our understanding of this novel virus. The knowledge gained through ongoing studies on CHV’s pathogenesis, its potential as a model for HCV, transmission dynamics, and replication mechanisms will undoubtedly shape the future of veterinary and human medicine. By leveraging these insights, researchers can develop effective preventive and therapeutic strategies to improve the health and well-being of canines and potentially combat related viral infections in humans.

Canine Hepacivirus in Worldwide Canid Populations
Canine hepacivirus (CHV) has a global presence among canid populations, including dogs, coyotes, foxes, wolves, bears, and skunks. The prevalence of CHV varies across different regions, highlighting the need for further research to determine the global distribution of the virus and understand its impact on canid health.
Studies have detected CHV in canids around the world, indicating that the virus is not limited to domestic dogs. This finding raises important questions about the transmission dynamics and potential reservoirs of CHV in the wild. Further investigation is warranted to elucidate the epidemiology and ecological interactions of CHV within canid populations.
The knowledge gained from studying CHV in different canid species can provide valuable insights into the biology, transmission, and host-pathogen interactions of this viral infection. Understanding the prevalence of CHV in worldwide canid populations is crucial for assessing the risk to domestic dogs and wildlife, as well as informing disease management and prevention strategies.
Canine Hepacivirus Prevalence in Canid Populations
Research efforts have focused on determining the prevalence of CHV in diverse canid populations across the globe. These investigations involve surveillance studies, molecular detection methods, and serological assays to identify the presence of CHV and assess the rate of infection.
A comprehensive understanding of CHV prevalence in different canid species can provide valuable information on the susceptibility, transmission routes, and potential reservoirs of the virus. This data can contribute to the development of targeted control measures and interventions to mitigate the spread of CHV.
Global Distribution of Canine Hepacivirus
The global distribution of CHV remains a topic of ongoing research. Monitoring and surveillance studies are essential for mapping the geographic distribution of CHV and understanding the factors influencing its spread.
The distribution of CHV may vary depending on several factors, including climate, population density, and the presence of other viral infections. Investigating the global distribution of CHV can provide insight into the factors influencing its prevalence and shed light on potential risk factors for infection in different regions.
Implications for Canid Health
The detection and characterization of CHV in canid populations worldwide have important implications for canid health. Understanding the prevalence of CHV and its potential impact on canids can aid in the development of effective disease management and prevention strategies.
By studying the global distribution of CHV, researchers can identify areas of high prevalence and potential hotspots for CHV transmission. This information can guide targeted surveillance and intervention efforts to reduce the burden of CHV in canid populations.
As our knowledge of CHV in worldwide canid populations grows, it is crucial to continue collaborative research efforts to better understand the epidemiology, impact, and control measures for this viral infection.
img {
display: block;
margin-left: auto;
margin-right: auto;
max-width: 80%;
height: auto;
}
Canine Hepacivirus and Other Canine Diseases
Canine hepacivirus (CHV) is not only implicated in canine chronic hepatitis but can also potentially contribute to other canine diseases and health complications. One significant aspect is its ability to co-infect dogs with other viral or bacterial respiratory pathogens, leading to more severe respiratory infections.
Dogs infected with CHV may be more susceptible to respiratory diseases caused by pathogens such as canine respiratory coronavirus (CRCoV), canine influenza virus (CIV), canine parainfluenza virus (CPIV), or Bordetella bronchiseptica. The presence of CHV as a co-infection could exacerbate the severity and duration of respiratory symptoms, posing greater challenges in the diagnosis, treatment, and management of these cases.
Investigating the presence of CHV in dogs with other diseases, such as canine chronic hepatitis, is also essential to better understand its impact on canine health. Researchers are exploring the potential association between CHV and other canine conditions to assess any potential synergistic effects that could exacerbate the disease progression.
Co-Infections with CHV
Co-infections involving CHV and other pathogens are particularly concerning due to the potential for heightened pathology and a more significant impact on the affected dogs’ overall health. Respiratory infections in dogs are a common occurrence, and the involvement of CHV as a co-infecting agent emphasizes the need for comprehensive diagnostic strategies and appropriate management approaches.
When co-infections occur, the disease picture can become more complex, making it challenging to develop effective treatments and preventive measures. Therefore, it is crucial to consider the possibility of CHV co-infections when faced with respiratory infections in dogs to ensure comprehensive and accurate diagnoses.
“Understanding the impacts of canine hepacivirus co-infections is vital for canine health professionals to provide appropriate care, treatment, and guidance. By studying the interactions between CHV and other pathogens, we can develop tailored approaches to manage the diseases and further improve overall canine health.”
Research and Future Directions
Future research endeavors should focus on investigating the prevalence of co-infections involving CHV and other respiratory pathogens to gain a deeper understanding of their clinical significance and potential implications. Identifying specific synergistic effects and interactions between CHV and other pathogens can provide valuable insights into disease mechanisms and guide the development of effective preventive strategies.
Furthermore, by studying the interactions between CHV and other diseases, such as canine chronic hepatitis, researchers can uncover potential links and interactions that significantly impact the overall health of dogs. This knowledge can then inform the development of targeted interventions and management approaches to mitigate the negative consequences and maximize positive health outcomes.
Exploring the interplay between CHV and other canine diseases is a promising avenue for future research, ultimately aiming to enhance the overall well-being and quality of life for dogs.
Canine Hepacivirus and Canine Immune Response
The immune response to canine hepacivirus is a subject that requires further investigation. Research has shown the presence of anti-CHV antibodies in serum samples taken from dogs with chronic hepatitis, indicating an immune response to the virus.
Understanding the immune response to canine hepacivirus is crucial in developing strategies for preventing and managing viral infections in dogs. By studying how CHV interacts with the canine immune system, researchers can gain valuable insights into the mechanisms of viral infections and immunity in canines.
With a better understanding of the immune response, scientists can explore potential avenues for the development of effective vaccines and antiviral treatments targeting CHV. These advancements could significantly contribute to improving the health and well-being of dogs affected by hepacivirus and other viral infections.
It is worth noting that the specific immune mechanisms involved in CHV infection and the development of protective immunity remain unknown. Further research is needed to uncover the intricacies of the canine immune response to hepacivirus.
“The immune response to canine hepacivirus is an area of ongoing research. By studying the specific immune mechanisms involved, we can gain valuable insights into viral infections and immunity in canines.”
Canine Hepacivirus and Canine Virology Research
Canine hepacivirus (CHV) presents a unique opportunity for groundbreaking canine virology research. With its close genetic relation to hepatitis C virus (HCV), CHV can serve as a valuable model for studying HCV infection in humans. By investigating CHV, researchers can deepen their understanding of viral replication, immune response, and pathogenesis in dogs, facilitating the development of effective treatments for various viral infections.
The study of CHV enables scientists to explore the intricate mechanisms of viral replication in canine hosts. Understanding how CHV replicates and interacts with the canine immune system can provide crucial insights into the broader field of virology. These insights may extend beyond CHV and contribute to advancements in the prevention and treatment of viral diseases that affect both humans and animals.
“Canine hepacivirus is an excellent model for studying viral replication and immune response in dogs, which can have significant implications for our understanding of other viral infections.”
Furthermore, investigating the immune response to CHV infection helps researchers uncover novel strategies for combating viral diseases. By studying CHV-infected dogs, scientists can identify immune markers and pathways that play a vital role in controlling viral infections. These findings may pave the way for the development of innovative immunotherapies that enhance the immune response to combat various viral pathogens.
CHV as a Model for HCV
One of the most exciting aspects of CHV research is its potential as a model for studying HCV infection in humans. With their shared genetic characteristics, CHV and HCV offer a unique opportunity to explore the fundamental mechanisms of viral hepatitis. By leveraging CHV as a model, researchers can gain valuable insights into the pathogenesis and transmission of HCV, contributing to the development of novel therapeutic approaches and preventive strategies for human infections.
“The study of CHV provides a bridging platform between canine and human virology, offering crucial insights into the pathogenesis and replication of HCV in humans.”
Viral Replication Studies
Viral replication studies are a vital component of canine virology research. By investigating how CHV replicates within canine cells, scientists can unravel the intricate molecular mechanisms driving viral propagation. Understanding the nuances of CHV replication can foster a deeper comprehension of viral infection processes, further improving our ability to combat a wide range of viral diseases.
To successfully study viral replication, researchers employ innovative techniques such as cell culture systems and molecular assays. These methods allow them to observe and analyze the key stages of viral replication, shedding light on the processes that ensure the virus’s survival and dissemination within the host.
| Benefits of Canine Virology Research | Implications for Human Health |
|---|---|
| Enhancing our understanding of viral replication processes | Potential development of innovative antiviral therapies |
| Identification of immune markers and pathways | Inspiring novel immunotherapeutic strategies |
| Modeling HCV infection in humans | Contributing to the understanding of HCV pathogenesis |
Canine virology research and CHV studies hold immense promise for advancing our knowledge of viral infections and their impacts on both canine and human health. By investigating viral replication, studying CHV as a model for HCV, and exploring the intricate details of viral pathogenesis, researchers pave the way for breakthroughs in the prevention and treatment of viral diseases, benefiting both human and canine populations.
Conclusion
In conclusion, canine hepacivirus (CHV) is a fascinating and relatively new virus that exhibits genetic similarities to hepatitis C virus (HCV). Although CHV does not pose a risk to human health, its discovery has provided valuable insights into the origins and transmission of HCV. Ongoing research on CHV is shedding light on the impact of the virus on canine health and its potential as a model for studying HCV infections in humans.
The investigation of CHV has uncovered important information about canine chronic hepatitis and its potential association with liver disease in dogs. While no definitive conclusions can be drawn at this time, the existing research serves as a foundation for future studies exploring the intricate relationship between CHV and canine chronic hepatitis.
To fully understand the impact of CHV on canine health and its potential benefits as a research model for HCV, further studies are needed. Ongoing research efforts are focused on elucidating the pathogenesis of CHV, developing effective diagnostic methods, and exploring potential prevention and treatment strategies. These advancements will not only contribute to our understanding of viral infections in dogs but may also have implications for the diagnosis and management of HCV infections in humans.
FAQ
What is canine hepacivirus (CHV) and its relationship to canine chronic hepatitis?
Canine hepacivirus has been identified as the closest genetic relative to hepatitis C virus (HCV) in dogs. While canine chronic hepatitis is a common disease in dogs, no studies have determined if CHV is involved in the development of liver disease in dogs.
How is canine hepacivirus transmitted, and what are the clinical signs of infection?
Canine hepacivirus can be transmitted through direct contact with infected saliva, feces, urine, and contaminated fomites. The virus primarily infects the respiratory tract, and clinical signs can include fever, lethargy, inappetence, vomiting, hemorrhagic diarrhea, abdominal pain, dehydration, conjunctivitis, cough, corneal edema, and rarely icterus or neurologic signs.
Can humans be infected with canine hepacivirus?
No, canine hepacivirus is not known to infect humans and is not considered a zoonotic disease. However, the discovery of CHV has provided valuable insights into the origin of HCV.
How is canine hepacivirus detected and diagnosed?
Canine hepacivirus can be detected using PCR assays that target specific regions of the virus’s genome. These tests can be performed on liver samples to identify viral nucleic acids. Serological tests, such as luciferase immunoprecipitation system (LIPS) assays, can also be used to screen serum samples for the presence of anti-CHV antibodies.
Are there any specific vaccines or treatments available for canine hepacivirus?
Currently, there are no specific vaccines or antiviral treatments available for canine hepacivirus. The best strategy for managing the disease is to prevent exposure through proper hygiene and vaccination against other common canine viral infections.
What is the current state of research on canine hepacivirus?
Canine hepacivirus research is still in its early stages, and further studies are needed to understand the pathogenesis of CHV in dogs and its potential as an animal model for HCV-induced liver disease in humans. Transmission studies and research on CHV replication and pathogenesis in cell cultures are important areas of investigation.
Where is canine hepacivirus found, and what is its impact on canid health?
Canine hepacivirus has been detected in canid populations worldwide, including dogs, coyotes, foxes, wolves, bears, and skunks. The prevalence of CHV varies among different regions, and further studies are needed to determine the global distribution of the virus and its impact on canid health.
How does canine hepacivirus interact with other diseases in dogs?
Canine hepacivirus can potentially co-infect dogs with other viral or bacterial respiratory pathogens, leading to more severe respiratory infections. The presence of CHV in dogs with other diseases, such as canine chronic hepatitis, should also be investigated to understand its impact on overall canine health.
What is known about the immune response to canine hepacivirus infection?
Studies have shown the presence of anti-CHV antibodies in serum samples from dogs with chronic hepatitis, indicating an immune response to the virus. However, further research is needed to determine the specific immune mechanisms involved in CHV infection and the development of protective immunity.
How can canine hepacivirus contribute to canine virology research?
Canine hepacivirus provides a unique opportunity for canine virology research and as a potential model for studying HCV infection in humans. The study of CHV can contribute to a better understanding of viral replication, immune response, and pathogenesis in dogs, which can have implications for the development of treatments for other viral infections.
What is the conclusion of current research on canine hepacivirus?
Canine hepacivirus is a novel virus that shares genetic similarities with hepatitis C virus. While it does not infect humans, the discovery of CHV has provided valuable insights into the origin and transmission of HCV. Research on CHV is ongoing, and further studies are needed to fully understand the impact of the virus on canine health and its potential as a model for HCV research.